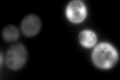
YGL135W
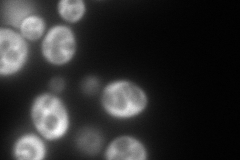
YGL135W
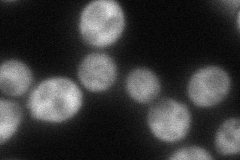
YGL135W
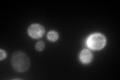
YGL135W

View description
N-terminally acetylated protein component of the large (60S) ribosomal subunit, nearly identical to Rpl1Ap and has similarity to E. coli L1 and rat L10a ribosomal proteins; rpl1a rpl1b double null mutation is lethal
Localization:
Intensity:
Fold change:
Significance:
-
C’ GFP library in SD
cytosol599.58 -
N' NOP1pr-GFP in SD
cytosol435.087 -
N' TEF2pr-mCherry in SD

cytosol382.299 -
N' NATIVEpr-GFP in SD

cytosol1075.16 -
N' TEF2pr-VC and Cyto-VN in SD
cytosol88.1666 -
C’ GFP library in SD+DTT

cytosol282.670.47Yes -
C’ GFP library in SD+H2O2

cytosol655.831.09No -
C’ GFP library in Starvation Media
cytosol282.670.47Yes -
C’ GFP library on the background of Pup2-DaMP

cytosol -
C’ GFP library on the background of CCT mutant

cytosol952.3721.58837Yes
